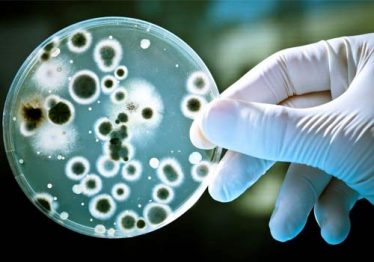

Alarm and Alarm System Glossary
Your Education and Training School, which Can Lead to Industry Certification:
The Building Restoration Institute, Inc. (BRI) instructs open (available to anyone that is qualified) courses along with closed (private) small personalized courses.Depending on the course and prerequisites, they will be taught “in person” or in a webinar. BRI’s current courses include:

American Rug Glossary
The American
Glossary of Rugs
Accent rug (Scatter rug) – Small rugs placed in strategic places to add warmth and color. Accent rugs are found next to a bed, in a bathroom, hallway, kitchen, or in front of a fireplace. They are usually placed on bare floors, but they can be found over wall-to-wall

Oriental and Persian Rug Glossary
HISTORY AND GLOSSARY OF ORIENTAL AND PERSIAN RUG WEAVING
During the months of research, compiling information for this glossary, I fell in love with people and cultures I know extraordinarily little about. I see them through my four monitors that take up the desk. One monitor may be opened to Google maps that points out the location of an
Microbiology, Medical and
Industry Terms for the IH and Restorer
Your Education and Training School, which Can Lead to Industry Certification:
Abnormal spore trap readings (environmental mold spore testing) – Air samples of spores, usually mold spores, which are: higher in the total number of spores, a shift in fungal ecology, or both. The interpretation of abnormal spore trap readings is made based on comparison control sample(s).

Mold Damage
Remediation Glossary
Building Science, Worker Health and Safety, Industry Standards and Best Practices
Abatement – (1) The action of minimizing the presence and danger of hazardous material such as lead and asbestos, bacteria, and mold, by reducing the amount, degree, and intensity. (2) In water damage or sewage backup situations, abatement is the ability of restorers to contain, control and eliminate sources of water

Occupational and Industrial
Hygiene Glossary
BASIC OCCUPATIONAL AND INDUSTRIAL HYGIENE Glossary with EPA, OSHA, ACGIH and Other Industry Terms and Definitions
AAIH – American Academy of Industrial Hygiene.
Absorb vs. Adsorb – Absorb is the “sucking up” of a material into a substance. Adsorb is the “sticking” of a material to the surface of a substance.Absorption – The process of one

Water Damage Restoration
Building Science, Worker Health and Safety, Industry Standards and Best Practices
Abatement – (1) The action of minimizing the presence and danger of hazardous material such as lead and asbestos, bacteria, and mold, by reducing the amount, degree and intensity. (2) In water damage or sewage backup situations, abatement is the ability of restorers to contain, control and eliminate sources of water

Wildfire
Wildfire Firefighter’s
Glossary
A-wagon – This is another all purpose, regional, term. Often A-wagon is applied to vehicles designed to fight grass or brush fires. Although some departments may use this term to describe hazardous materials apparatus. In these cases, they can pump foam or other specialized agents for the control of particular types of fires.

Wildfire
Wildfire
Glossary
In 2009, I completed a non-scientific survey of environmental professionals, restorers and adjusters who attended my fire and smoke damage restoration class, where I found all three groups are using different interpretations of definitions to describe fire damaged and wildfire smoke, soot, char and ash

Wildfire
Wildfire Glossary for Environmental Professionals, Adjusters and Restorers
Abatement – The action of minimizing or removing the presence of a hazardous material such as asbestos and lead paint. (See: Cleaning; Mitigation; Restoration)
Abatement, fire – (1) The action of minimizing the presence and danger of hazardous material such as lead and asbestos, bacteria, and mold, by reducing the amount, degree, and intensity.

Wildfire
Wildfire Impact Assessments Completed by an Industrial Hygienist and Other Qualified Experts
After a Wildfire, Do I need to hire an industrial hygienist and other qualified experts? “It Depends” is the answer, which sounds vague, but it is not.
